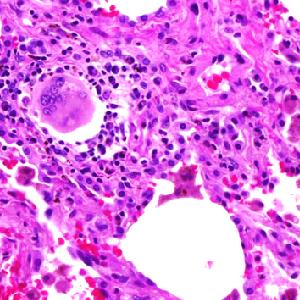

Degommier auramina fenicata
Soluzione decolorante
6 x 500 ml
La documentazione sarà disponibile a breve, nel frattempo potete contattarci via mail a specialist@histoline.com